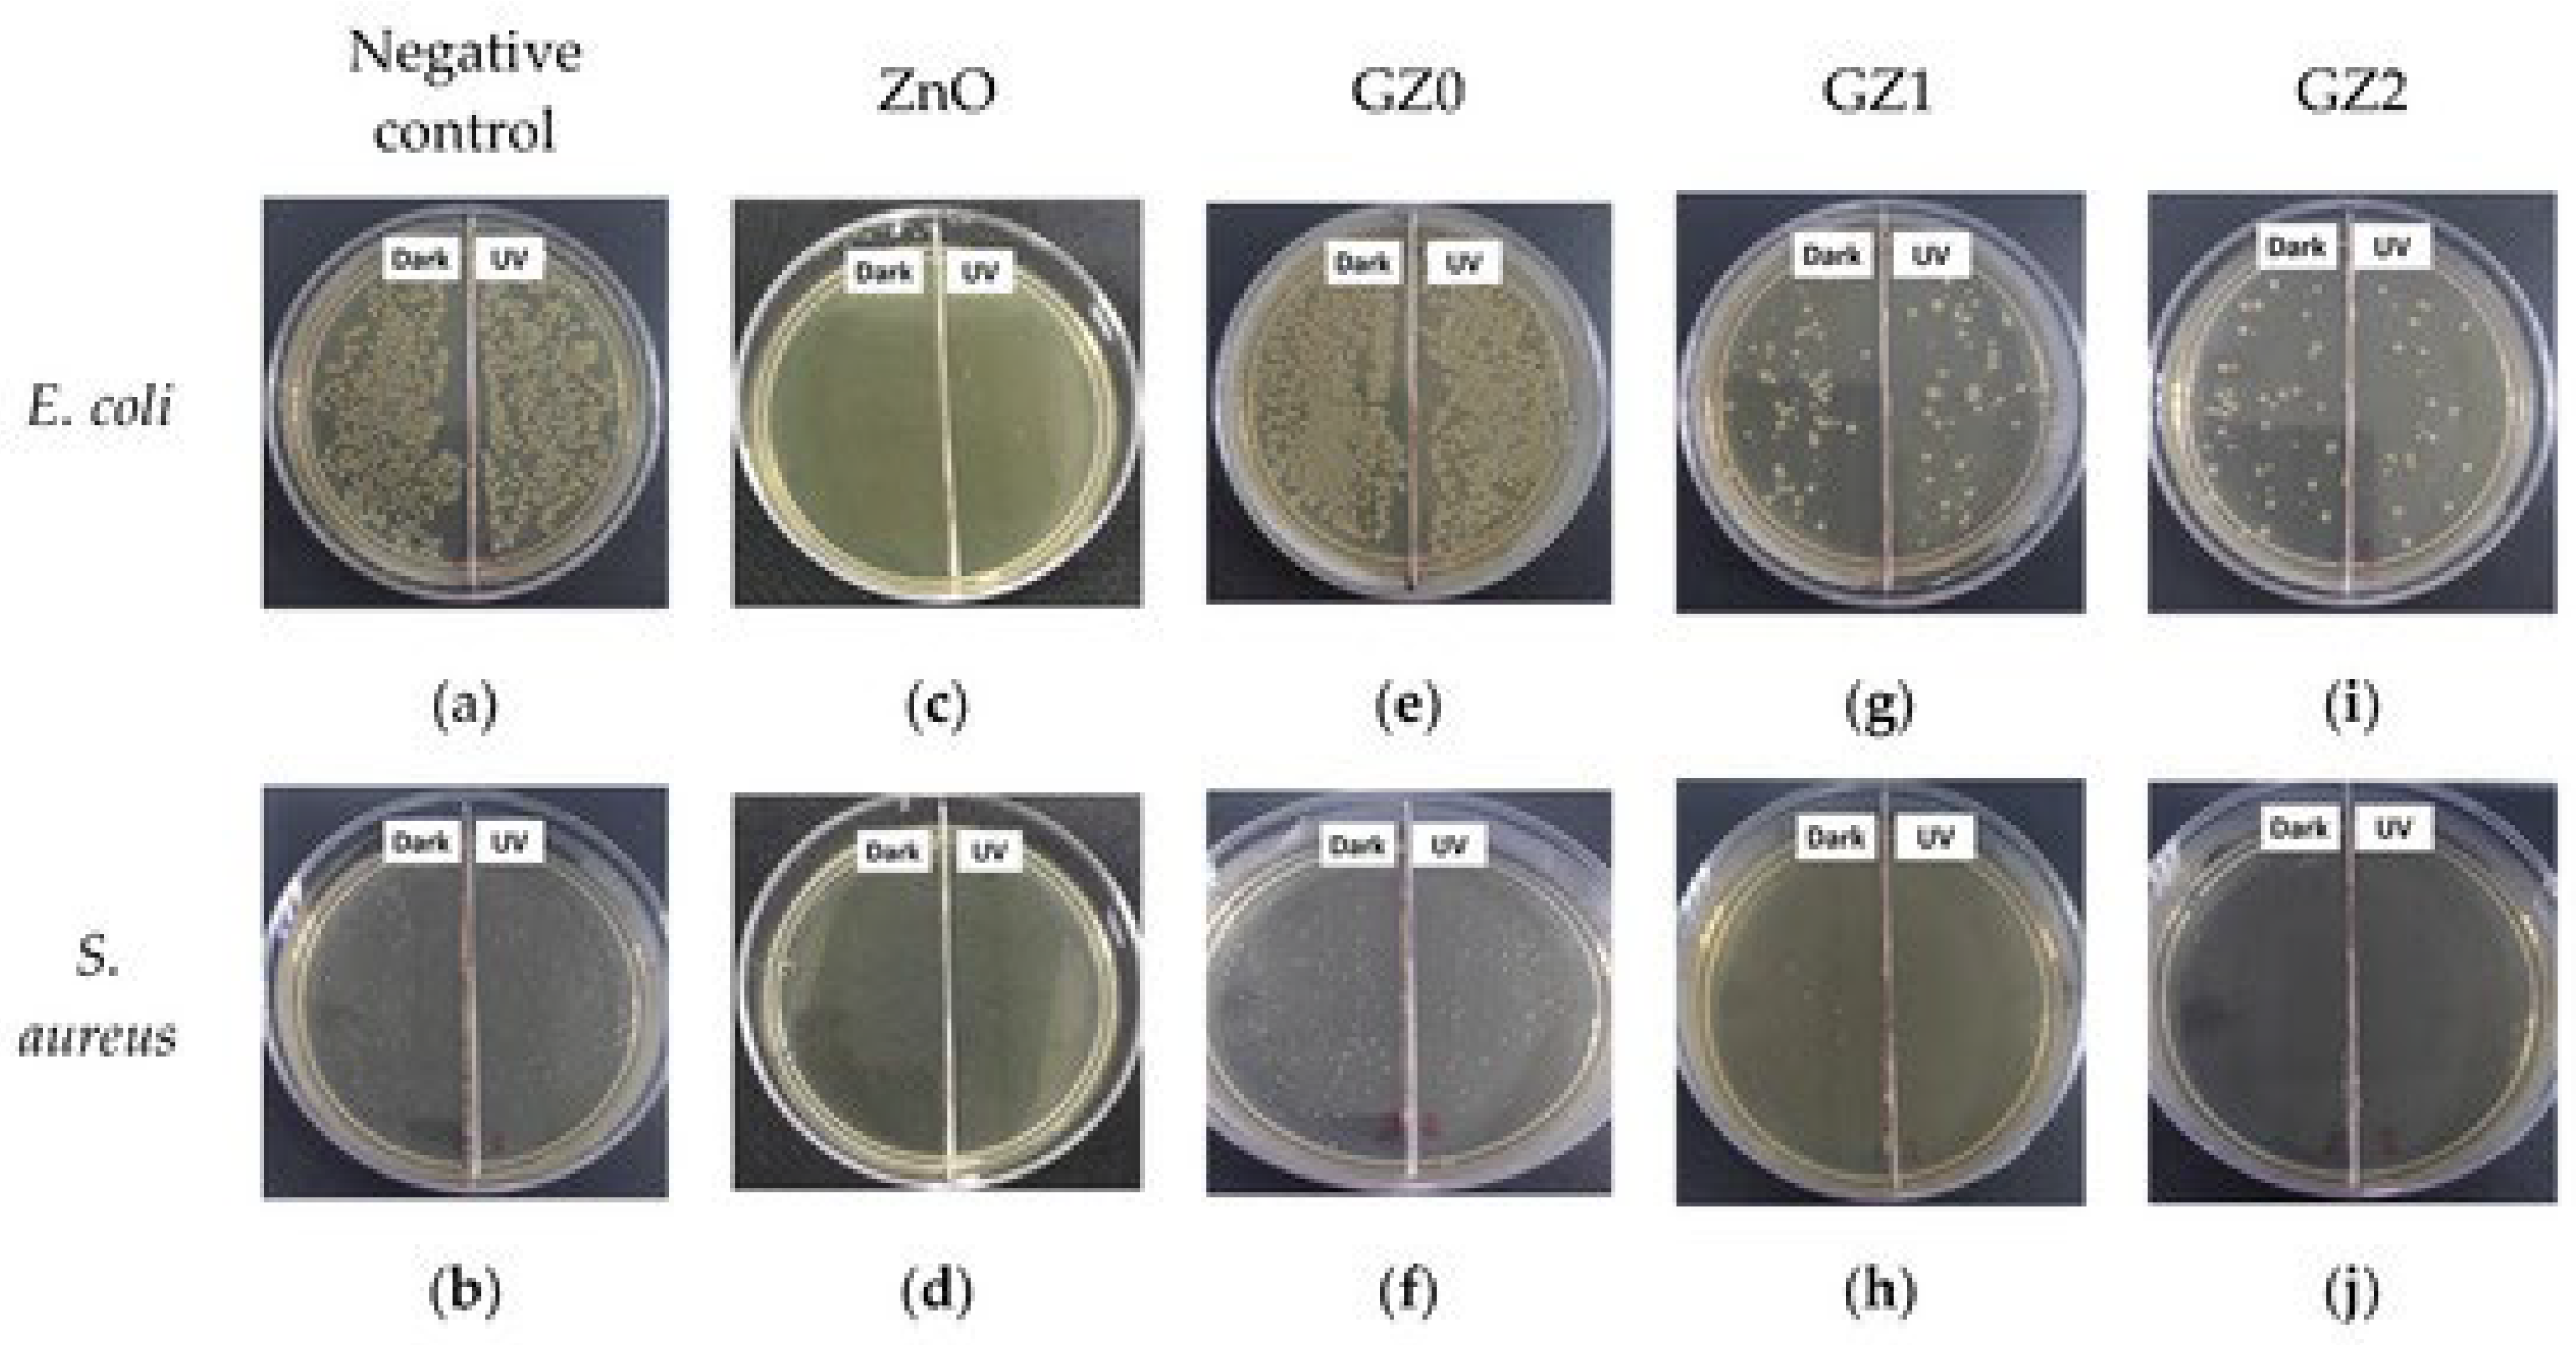
Ijms 24 01629 g008 Ijms 24 01629 g008
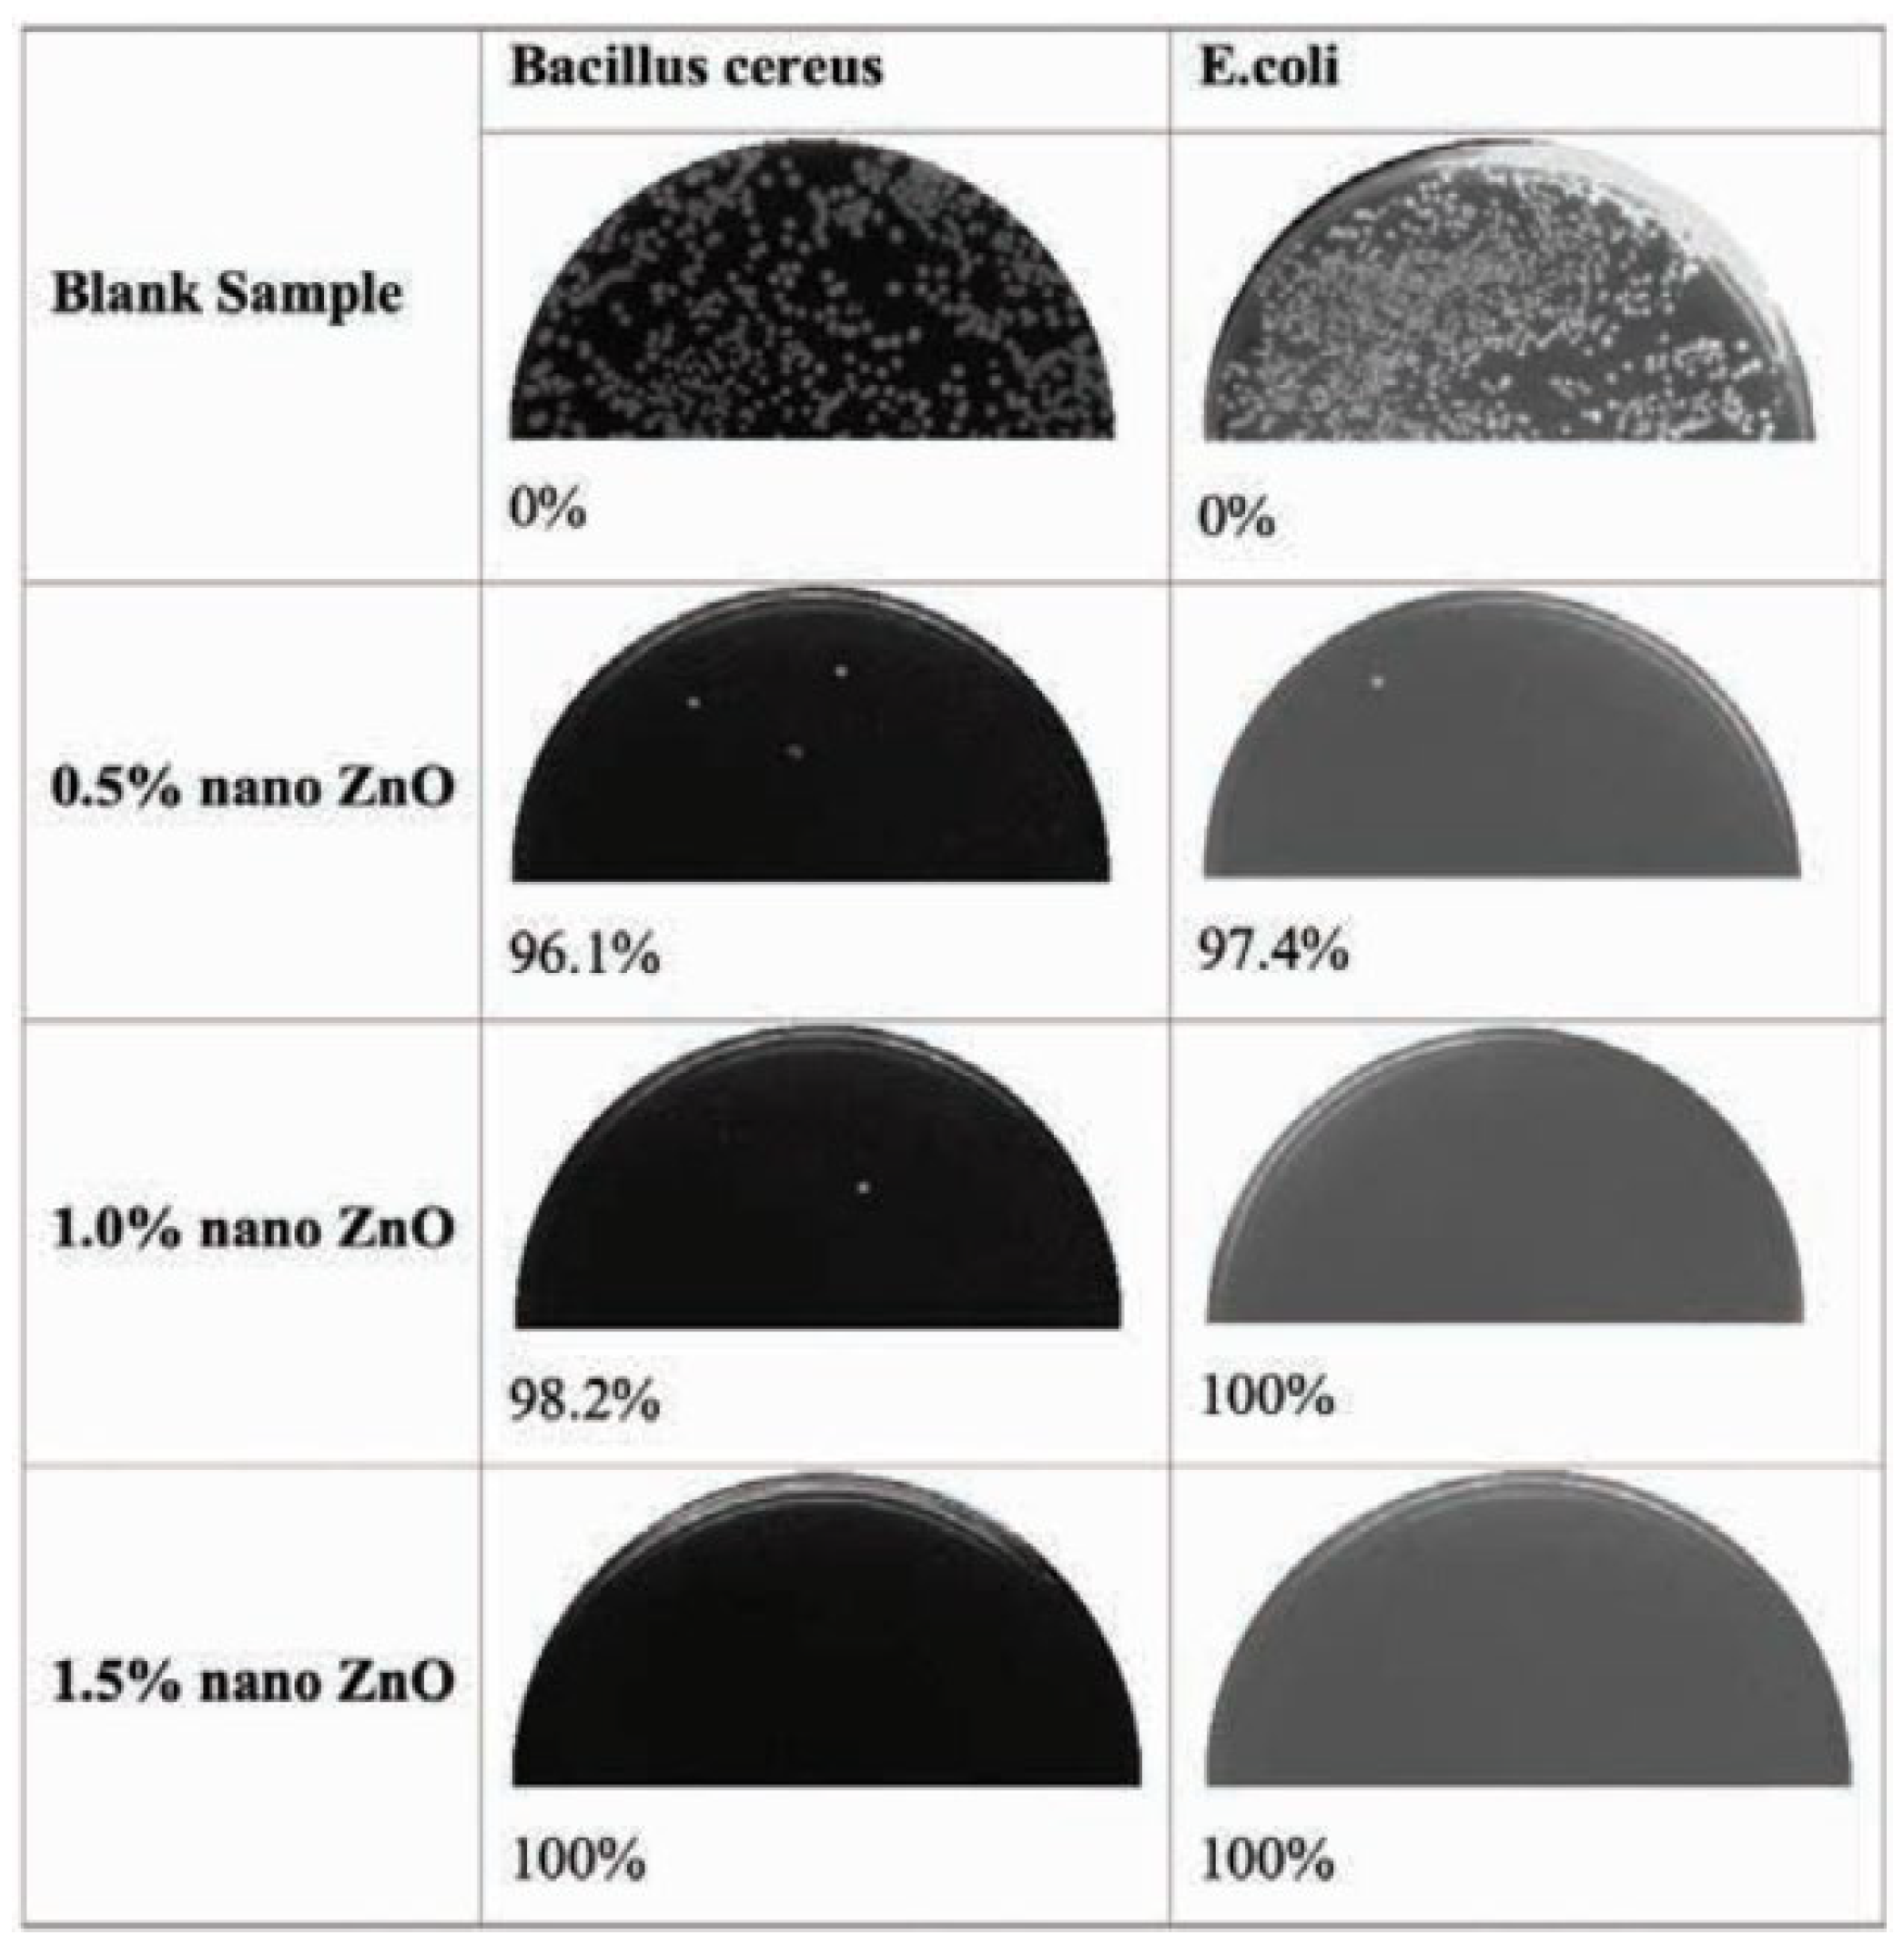
Ijms 24 01629 g007 Ijms 24 01629 g007
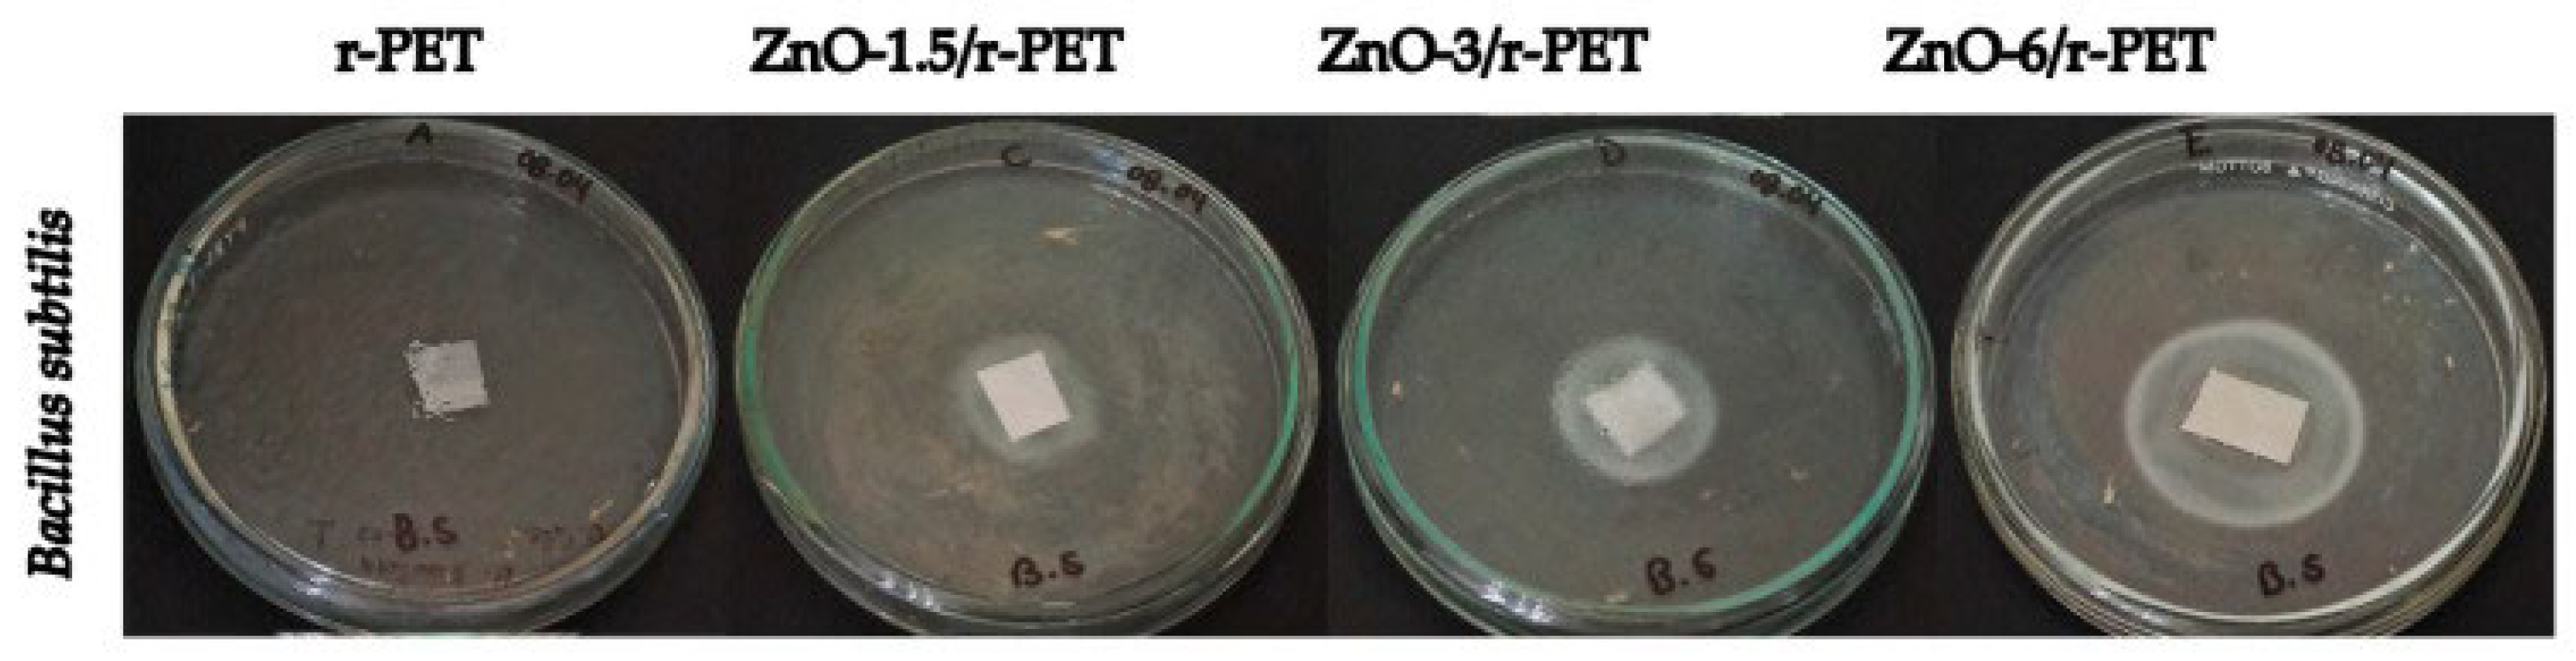
Ijms 24 01629 g010 Ijms 24 01629 g010
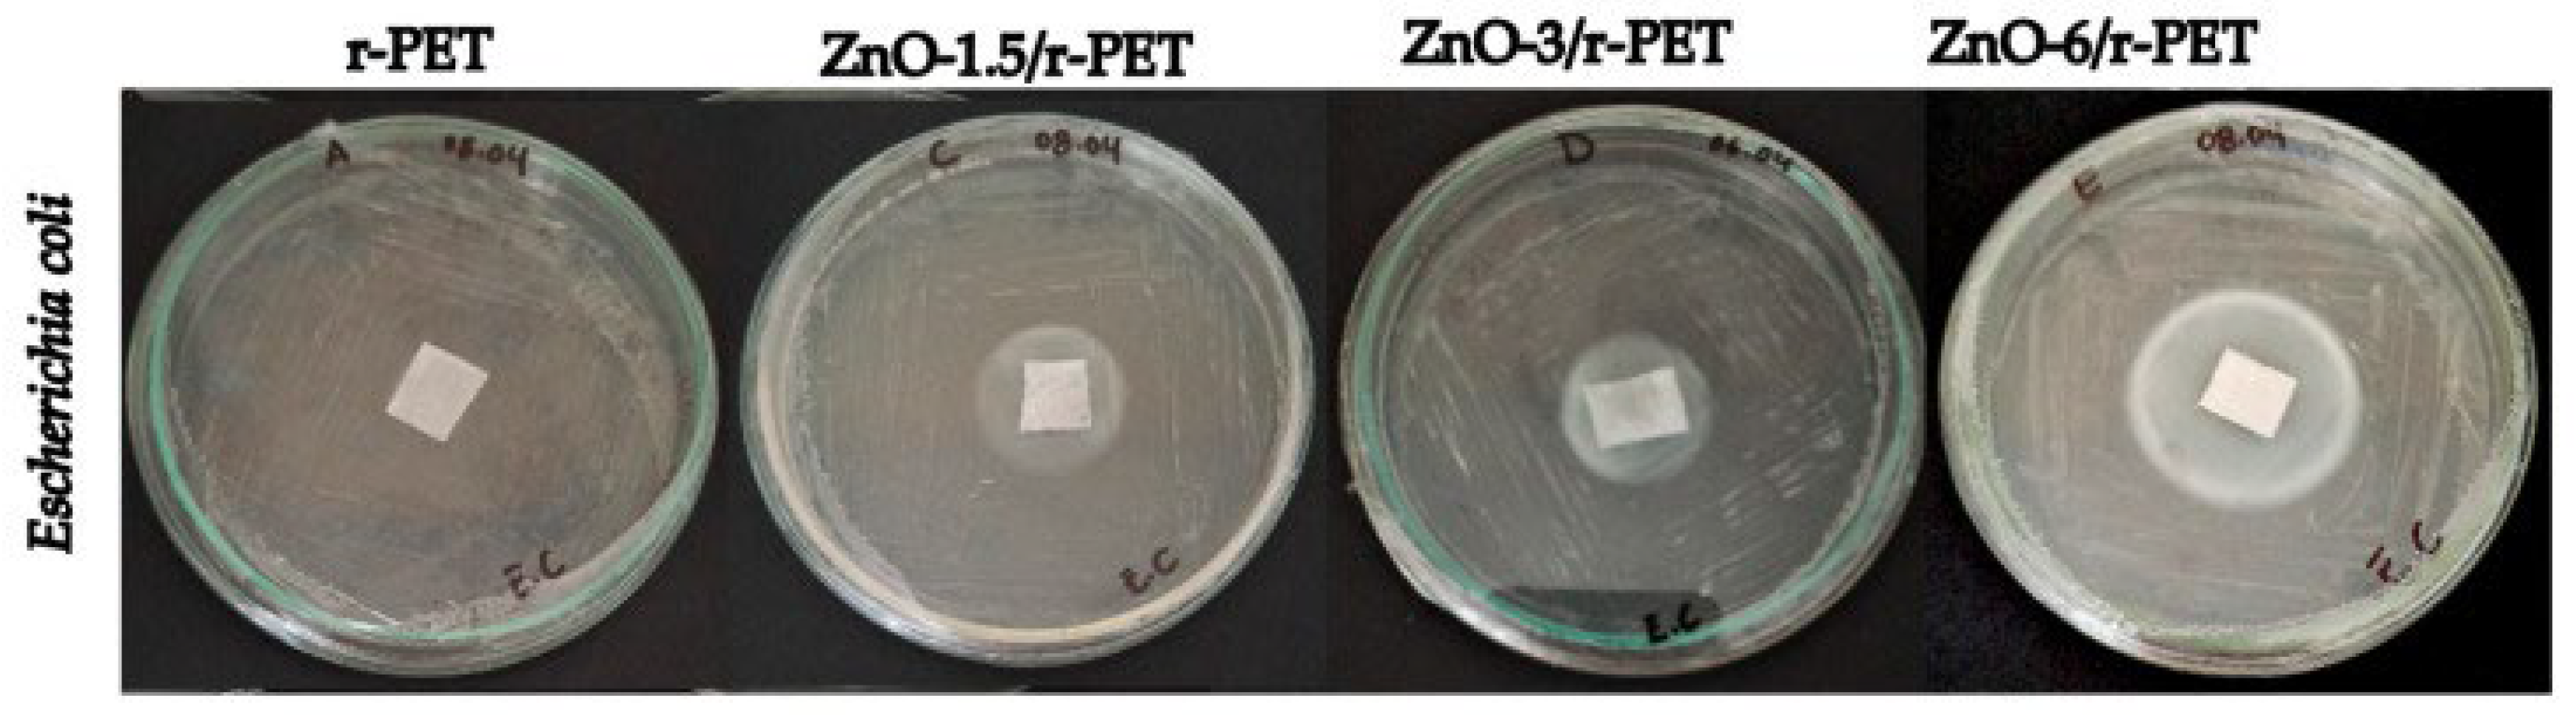
Ijms 24 01629 g011 Ijms 24 01629 g011

Antimicrobial Clothing Based on Electrospun Fibers with ZnO Nanoparticles
Abstract
1. Introduction
1.1. Electrospinning

1.2. Zinc Oxide
1.3. Electrospun Fibers
1.4. Protective Clothing
2. Design of Antimicrobial Composite Fibers Based on Electrospun Polymers and Inorganic Nanoparticles
3. Approaches for Designing Fibrous Composite Materials by Electrospinning and Related Techniques
4. Antimicrobial Nanoparticles and Their Influence on the Creation and Final Characteristics of (Bio)Polymeric Fibers
5. Conclusions
Author Contributions
Funding
Institutional Review Board Statement
Informed Consent Statement
Data Availability Statement
Conflicts of Interest
References
- Xue, J.; Wu, T.; Dai, Y.; Xia, Y. Electrospinning and Electrospun Nanofibers: Methods, Materials, and Applications. Chem. Rev. 2019, 119, 5298. [Google Scholar] [CrossRef] [PubMed]
- Afrash, H.; Nazeri, N.; Davoudi, P.; FaridiMajidi, R.; Ghanbari, H. Development of a Bioactive Scaffold based on NGF Containing PCL/Chitosan Nanofibers for Nerve Regeneration. Biointerface Res. Appl. Chem. 2021, 11, 12606–12617. [Google Scholar] [CrossRef]
- Li, Y.; Zhu, J.; Cheng, H.; Li, G.; Cho, H.; Jiang, M.; Gao, Q.; Zhang, X. Developments of Advanced Electrospinning Techniques: A Critical Review. Adv. Mater. Technol. 2021, 6, 2100410. [Google Scholar] [CrossRef]
- Dziemidowicz, K.; Sang, Q.; Wu, J.; Zhang, Z.; Zhou, F.; Lagaron, J.M.; Mo, X.-M.; Parker, G.J.M.; Yu, D.-G.; Zhu, L.-M.; et al. Electrospinning for healthcare: Recent advancements. J. Mater. Chem. B 2021, 9, 939–951. [Google Scholar] [CrossRef] [PubMed]
- Wang, Y.; Yokota, T.; Someya, T. Electrospun nanofiber-based soft electronics. NPG Asia Mater. 2021, 13, 22. [Google Scholar] [CrossRef]
- Li, Y.; Abedalwafa, M.A.; Tang, L.; Wang, L. Electrospun Nanofibers for Sensors. In Electrospinning: Nanofabrication and Applications; William Andrew: Norwich, NY, USA, 2019; pp. 571–601. [Google Scholar] [CrossRef]
- Waldrop, K.; Wycisk, R.; Pintauro, P.N. Application of electrospinning for the fabrication of proton-exchange membrane fuel cell electrodes. Curr. Opin. Electrochem. 2020, 21, 257–264. [Google Scholar] [CrossRef]
- Shahriar, S.M.S.; Mondal, J.; Hasan, M.N.; Revuri, V.; Lee, D.Y.; Lee, Y.-K. Electrospinning Nanofibers for Therapeutics Delivery. Nanomaterials 2019, 9, 532. [Google Scholar] [CrossRef]
- Memic, A.; Abudula, T.; Mohammed, H.S.; Joshi Navare, K.; Colombani, T.; Bencherif, S.A. Latest Progress in Electrospun Nanofibers for Wound Healing Applications. ACS Appl. Bio Mater. 2019, 2, 952–969. [Google Scholar] [CrossRef]
- Rahmati, M.; Mills, D.K.; Urbanska, A.M.; Saeb, M.R.; Venugopal, J.R.; Ramakrishna, S.; Mozafari, M. Electrospinning for tissue engineering applications. Prog. Mater. Sci. 2021, 117, 100721. [Google Scholar] [CrossRef]
- Maliszewska, I.; Czapka, T. Electrospun Polymer Nanofibers with Antimicrobial Activity. Polymers 2022, 14, 1661. [Google Scholar] [CrossRef]
- Blachowicz, T.; Ehrmann, A. Recent developments in electrospun ZnO nanofibers: A short review. J. Eng. Fibers Fabr. 2020, 15, 1558925019899682. [Google Scholar] [CrossRef]
- Hashemi, H.; Rahimzadeh, G.; Saeedi, M.; Ghadami, F.; Rafati, A.; Gill, P. Ultra-Structural Characteristics of Aloe vera-Based Nanofibers as MRSA-Phage Nanocarriers. Biointerface Res. Appl. Chem. 2022, 12, 2152–2161. [Google Scholar] [CrossRef]
- Wang, C.; Wang, J.; Zeng, L.; Qiao, Z.; Liu, X.; Liu, H.; Zhang, J.; Ding, J. Fabrication of Electrospun Polymer Nanofibers with Diverse Morphologies. Molecules 2019, 24, 834. [Google Scholar] [CrossRef]
- Sharma, P.; Hasan, M.R.; Mehto, N.K.; Deepak; Bishoyi, A.; Narang, J. 92 years of zinc oxide: Has been studied by the scientific community since the 1930s—An overview. Sens. Int. 2022, 3, 100182. [Google Scholar] [CrossRef]
- Kedruk, Y.Y.; Baigarinova, G.A.; Gritsenko, L.; Cicero, G.; Abdullin, K.A. Facile Low-Cost Synthesis of Highly Photocatalitycally Active Zinc Oxide Powders. Front. Mater. 2022, 9, 197. [Google Scholar] [CrossRef]
- MN, D.; Sood, R. Review on Synthesis and Applications of Zinc Oxide Nanoparticles. Preprints. 2021. Available online: https://www.preprints.org/manuscript/202105.0688/v1 (accessed on 27 August 2022).
- Krishnamoorthy, A. Review—The Importance of Zinc Oxide (ZnO) in Rubber Technology. Available online: https://www.researchgate.net/publication/328448662_Review_-_The_Importance_of_Zinc_Oxide_ZnO_in_Rubber_Technology (accessed on 27 August 2022).
- Pascariu, P.; Homocianu, M. ZnO-based ceramic nanofibers: Preparation, properties and applications. Ceram. Int. 2019, 45, 11158–11173. [Google Scholar] [CrossRef]
- Noman, M.T.; Amor, N.; Petru, M. Synthesis and applications of ZnO nanostructures (ZONSs): A review. Crit. Rev. Solid State Mater. Sci. 2021, 47, 99–141. [Google Scholar] [CrossRef]
- Kim, I.; Viswanathan, K.; Kasi, G.; Thanakkasaranee, S.; Sadeghi, K.; Seo, J. ZnO Nanostructures in Active Antibacterial Food Packaging: Preparation Methods, Antimicrobial Mechanisms, Safety Issues, Future Prospects, and Challenges. Food Rev. Int. 2020, 38, 537–565. [Google Scholar] [CrossRef]
- Subramaniam, V.D.; Prasad, S.V.; Banerjee, A.; Gopinath, M.; Murugesan, R.; Marotta, F.; Sun, X.-F.; Pathak, S. Health hazards of nanoparticles: Understanding the toxicity mechanism of nanosized ZnO in cosmetic products. Drug Chem. Toxicol. 2018, 42, 84–93. [Google Scholar] [CrossRef]
- Majumder, S.; Chatterjee, S.; Basnet, P.; Mukherjee, J. ZnO based nanomaterials for photocatalytic degradation of aqueous pharmaceutical waste solutions—A contemporary review. Environ. Nanotechnol. Monit. Manag. 2020, 14, 100386. [Google Scholar] [CrossRef]
- Droepenu, E.K.; Asare, E.A.; Dampare, S.B.; Adotey, D.K.; Gyampoh, A.O.; Kumi-Arhin, E. Laboratory and Commercial Synthesized Zinc Oxide Nanoparticles Adsorption onto Coconut Husk: Characterization, Isotherm, Kinetic, and Thermodynamic Studies. Biointerface Res. Appl. Chem. 2021, 11, 7871–7889. [Google Scholar] [CrossRef]
- CFR—Code of Federal Regulations Title 21. Available online: https://www.accessdata.fda.gov/scripts/cdrh/cfdocs/cfcfr/cfrsearch.cfm?fr=73.2991 (accessed on 27 August 2022).
- Raha, S.; Ahmaruzzaman, M. ZnO nanostructured materials and their potential applications: Progress, challenges and perspectives. Nanoscale Adv. 2022, 4, 1868–1925. [Google Scholar] [CrossRef] [PubMed]
- Cauda, V.; Gazia, R.; Porro, S.; Stassi, S.; Canavese, G.; Roppolo, I.; Chiolerio, A. Nanostructured ZnO Materials: Synthesis, Properties and Applications. In Handbook of Nanomaterials Properties; Springer: Berlin/Heidelberg, Germany, 2014; pp. 137–177. [Google Scholar] [CrossRef]
- Martínez-Carmona, M.; Gun’Ko, Y.; Vallet-Regí, M. ZnO Nanostructures for Drug Delivery and Theranostic Applications. Nanomaterials 2018, 8, 268. [Google Scholar] [CrossRef] [PubMed]
- Otuechere, C.A.; Adewuyi, A.; Ekozin, A.; Feng, X.; Cabrerizo, F.M. Green synthesized Zinc Oxide Nanoparticles Elicited a Prominent Suppression of Oxidative and Inflammatory Distortions in Rats Exposed to Carbon Tetrachloride. Biointerface Res. Appl. Chem. 2021, 12, 5444–5457. [Google Scholar] [CrossRef]
- Jiang, J.; Pi, J.; Cai, J. The Advancing of Zinc Oxide Nanoparticles for Biomedical Applications. Bioinorg. Chem. Appl. 2018, 2018, 1062562. [Google Scholar] [CrossRef]
- Bagga, S.; Akhtar, J.; Mishra, S. Synthesis and applications of ZnO nanowire: A review. In AIP Conference Proceedings; AIP Publishing: Long Island, NY, USA, 2018; Volume 1989. [Google Scholar] [CrossRef]
- Park, J.A.; Moon, J.; Lee, S.J.; Lim, S.C.; Zyung, T. Fabrication and characterization of ZnO nanofibers by electrospinning. Current Applied Physics 2009, 9, S210–S212. [Google Scholar] [CrossRef]
- Ekata, D.; Komal, A.; Salunkhe, A.; Shedage; Nerkar, A. Review on Nanoflowers. Available online: https://www.researchgate.net/publication/340715573_Review_on_Nanoflowers (accessed on 27 August 2022).
- Aspoukeh, P.K.; Barzinjy, A.A.; Hamad, S.M. Synthesis, properties and uses of ZnO nanorods: A mini review. Int. Nano Lett. 2021, 12, 153–168. [Google Scholar] [CrossRef]
- Theerthagiri, J.; Salla, S.; Senthil, R.; Nithyadharseni, P.; Madankumar, A.; Arunachalam, P.; Maiyalagan, T.; Kim, H.-S. A review on ZnO nanostructured materials: Energy, environmental and biological applications. Nanotechnology 2019, 30, 392001. [Google Scholar] [CrossRef]
- Rauwel, P.; Salumaa, M.; Aasna, A.; Galeckas, A.; Rauwel, E. A Review of the Synthesis and Photoluminescence Properties of Hybrid ZnO and Carbon Nanomaterials. J. Nanomater. 2016, 2016, 5320625. [Google Scholar] [CrossRef]
- Schaper, N.; Hutchinson, B.; Zustiak, S.; Kuljanishvili, I. Designing nano-biocomposite materials using CVD grown CNTs and ZnO nanostructures for hybrid interfaces and hydrogel environments with future biomedical applications. Bull. Am. Phys. Soc. 2020, 65, 1. [Google Scholar]
- Mishra, Y.K.; Adelung, R. ZnO tetrapod materials for functional applications. Mater. Today 2018, 21, 631–651. [Google Scholar] [CrossRef]
- Bhuiyan, M.R.A.; Mamur, H. A brief review on the synthesis of ZnO nanoparticles for biomedical applications. Iran. J. Mater. Sci. Eng. 2021, 18, 1–27. [Google Scholar] [CrossRef]
- Gilavand, F.; Saki, R.; Mirzaei, S.Z.; Lashgarian, H.E.; Karkhane, M.; Marzban, A. Green Synthesis of Zinc Nanoparticles Using Aqueous Extract of Magnoliae officinalis and Assessment of its Bioactivity Potentials. Biointerface Res. Appl. Chem. 2020, 11, 7765–7774. [Google Scholar] [CrossRef]
- Gudkov, S.V.; Burmistrov, D.E.; Serov, D.A.; Rebezov, M.B.; Semenova, A.A.; Lisitsyn, A.B. A Mini Review of Antibacterial Properties of ZnO Nanoparticles. Front. Phys. 2021, 9, 49. [Google Scholar] [CrossRef]
- Laurenti, M.; Cauda, V. ZnO Nanostructures for Tissue Engineering Applications. Nanomaterials 2017, 7, 374. [Google Scholar] [CrossRef]
- Alavi, M.; Nokhodchi, A. An overview on antimicrobial and wound healing properties of ZnO nanobiofilms, hydrogels, and bionanocomposites based on cellulose, chitosan, and alginate polymers. Carbohydr. Polym. 2020, 227, 115349. [Google Scholar] [CrossRef]
- Anjum, S.; Hashim, M.; Malik, S.A.; Khan, M.; Lorenzo, J.M.; Abbasi, B.H.; Hano, C. Recent Advances in Zinc Oxide Nanoparticles (ZnO NPs) for Cancer Diagnosis, Target Drug Delivery, and Treatment. Cancers 2021, 13, 4570. [Google Scholar] [CrossRef]
- Shetti, N.P.; Bukkitgar, S.D.; Reddy, K.R.; Reddy, C.V.; Aminabhavi, T.M. ZnO-based nanostructured electrodes for electrochemical sensors and biosensors in biomedical applications. Biosens. Bioelectron. 2019, 141, 111417. [Google Scholar] [CrossRef]
- Verma, R.; Pathak, S.; Srivastava, A.K.; Prawer, S.; Tomljenovic-Hanic, S. ZnO nanomaterials: Green synthesis, toxicity evaluation and new insights in biomedical applications. J. Alloy. Compd. 2021, 876, 160175. [Google Scholar] [CrossRef]
- Yu, Z.; Li, Q.; Wang, J.; Yu, Y.; Wang, Y.; Zhou, Q.; Li, P. Reactive Oxygen Species-Related Nanoparticle Toxicity in the Biomedical Field. Nanoscale Res. Lett. 2020, 15, 115. [Google Scholar] [CrossRef]
- Chen, F.-C.; Huang, C.-M.; Yu, X.-W.; Chen, Y.-Y. Effect of nano zinc oxide on proliferation and toxicity of human gingival cells. Hum. Exp. Toxicol. 2022, 41, 09603271221080236. [Google Scholar] [CrossRef] [PubMed]
- Wiesmann, N.; Mendler, S.; Buhr, C.R.; Ritz, U.; Kämmerer, P.W.; Brieger, J. Zinc Oxide Nanoparticles Exhibit Favorable Properties to Promote Tissue Integration of Biomaterials. Biomedicines 2021, 9, 1462. [Google Scholar] [CrossRef] [PubMed]
- Sun, Q.; Li, J.; Le, T. Zinc Oxide Nanoparticle as a Novel Class of Antifungal Agents: Current Advances and Future Perspectives. J. Agric. Food Chem. 2018, 66, 11209–11220. [Google Scholar] [CrossRef] [PubMed]
- Ferrone, E.; Araneo, R.; Notargiacomo, A.; Pea, M.; Rinaldi, A. ZnO Nanostructures and Electrospun ZnO–Polymeric Hybrid Nanomaterials in Biomedical, Health, and Sustainability Applications. Nanomaterials 2019, 9, 1449. [Google Scholar] [CrossRef] [PubMed]
- Naidu, K.C.B.; Kumar, N.S.; Banerjee, P.; Reddy, B.V.S. A review on the origin of nanofibers/nanorods structures and applications. J. Mater. Sci. Mater. Med. 2021, 32, 68. [Google Scholar] [CrossRef]
- Wang, L. Functional Nanofibre: Enabling Material for the Next Generation Smart Textiles. J. Fiber Bioeng. Inform. 2008, 1, 81–92. [Google Scholar] [CrossRef]
- Liu, L.; Xu, W.; Ding, Y.; Agarwal, S.; Greiner, A.; Duan, G. A review of smart electrospun fibers toward textiles. Compos. Commun. 2020, 22, 100506. [Google Scholar] [CrossRef]
- Fadil, F.; Affandi, N.; Misnon, M.; Bonnia, N.; Harun, A.; Alam, M. Review on Electrospun Nanofiber-Applied Products. Polymers 2021, 13, 2087. [Google Scholar] [CrossRef]
- Kamaci, U.D.; Peksel, A. Poly(vinyl alcohol)-based Electrospun Nanofibers: Characterization and Phytase Immobilization. Biointerface Res. Appl. Chem. 2021, 12, 7573–7583. [Google Scholar] [CrossRef]
- Beck, R.J.; Zhao, Y.; Fong, H.; Menkhaus, T.J. Electrospun lignin carbon nanofiber membranes with large pores for highly efficient adsorptive water treatment applications. J. Water Process Eng. 2017, 16, 240–248. [Google Scholar] [CrossRef]
- Aruchamy, K.; Mahto, A.; Nataraj, S. Electrospun nanofibers, nanocomposites and characterization of art: Insight on establishing fibers as product. Nano-Struct. Nano-Objects 2018, 16, 45–58. [Google Scholar] [CrossRef]
- Wu, S.; Dong, T.; Li, Y.; Sun, M.; Qi, Y.; Liu, J.; Kuss, M.A.; Chen, S.; Duan, B. State-of-the-art review of advanced electrospun nanofiber yarn-based textiles for biomedical applications. Appl. Mater. Today 2022, 27, 101473. [Google Scholar] [CrossRef]
- Egan, J.; Salmon, S. Strategies and progress in synthetic textile fiber biodegradability. SN Appl. Sci. 2021, 4, 22. [Google Scholar] [CrossRef]
- Liao, X.; Dulle, M.; Silva, J.M.D.S.E.; Wehrspohn, R.B.; Agarwal, S.; Förster, S.; Hou, H.; Smith, P.; Greiner, A. High strength in combination with high toughness in robust and sustainable polymeric materials. Science 2019, 366, 1376–1379. [Google Scholar] [CrossRef]
- Zhou, B.; Jiang, X.; Wang, R.; Yuan, X.; Liu, Y. Developments in Electrospinning of Nanofiber Yarns. J. Phys. Conf. Ser. 2021, 1790, 012081. [Google Scholar] [CrossRef]
- Ketabchi, N.; Dinarvand, R.; Adabi, M.; Gholami, M.; Firoozi, S.; Amanzadi, B.; Faridi-Majidi, R. Study of Third-Degree Burn Wounds Debridement and Treatment by Actinidin Enzyme Immobilized on Electrospun Chitosan/PEO Nanofibers in Rats. Biointerface Res. Appl. Chem. 2021, 11, 10358–10370. [Google Scholar] [CrossRef]
- Gorji, M.; Bagherzadeh, R.; Fashandi, H. Electrospun nanofibers in protective clothing. In Electrospun Nanofibers; Woodhead Publishing: Sawston, UK, 2017; pp. 571–598. [Google Scholar] [CrossRef]
- Protective Clothing Against Chemical and Biological Hazards—OSHWiki. Available online: https://oshwiki.eu/wiki/Protective_clothing_against_chemical_and_biological_hazards (accessed on 3 November 2022).
- PPE—Protective Clothing Guide Environmental Health and Safety. Available online: https://ehs.research.uiowa.edu/ppe-protective-clothing-guide (accessed on 3 November 2022).
- Bhuiyan, M.A.R.; Wang, L.; Shaid, A.; Shanks, R.; Ding, J. Advances and applications of chemical protective clothing system. J. Ind. Text. 2019, 49, 97–138. [Google Scholar] [CrossRef]
- Antunes, J.C.; Moreira, I.P.; Gomes, F.; Cunha, F.; Henriques, M.; Fangueiro, R. Recent Trends in Protective Textiles against Biological Threats: A Focus on Biological Warfare Agents. Polymers 2022, 14, 1599. [Google Scholar] [CrossRef]
- El-Kaliuoby, M.; Khalil, A.; El-Khatib, A.; Shehata, N. Antibacterial Synergism of Electrospun Nanofiber Mats Functioned with Silver Nanoparticles and Pulsed Electromagnetic Waves. Polymers 2021, 13, 277. [Google Scholar] [CrossRef]
- Hussein, M.A.M.; Ulag, S.; Dena, A.S.A.; Sahin, A.; Grinholc, M.; Gunduz, O.; El-Sherbiny, I.; Megahed, M. Chitosan/Gold Hybrid Nanoparticles Enriched Electrospun PVA Nanofibrous Mats for the Topical Delivery of Punica granatum L. Extract: Synthesis, Characterization, Biocompatibility and Antibacterial Properties. Int. J. Nanomed. 2021, 16, 5133. [Google Scholar] [CrossRef]
- Someswararao, M.; Dubey, R.; Subbarao, P. Electrospun composite nanofibers prepared by varying concentrations of TiO2/ZnO solutions for photocatalytic applications. J. Photochem. Photobiol. 2021, 6, 100016. [Google Scholar] [CrossRef]
- Haider, A.; Haider, S.; Kang, I.-K. A comprehensive review summarizing the effect of electrospinning parameters and potential applications of nanofibers in biomedical and biotechnology. Arab. J. Chem. 2018, 11, 1165–1188. [Google Scholar] [CrossRef]
- Mousa, H.M.; Hussein, K.H.; Sayed, M.M.; Abd El-Rahman, M.K.; Woo, H.-M. Development and Characterization of Cellulose/Iron Acetate Nanofibers for Bone Tissue Engineering Applications. Polymers 2021, 13, 1339. [Google Scholar] [CrossRef] [PubMed]
- Dodero, A.; Alloisio, M.; Vicini, S.; Castellano, M. Preparation of composite alginate-based electrospun membranes loaded with ZnO nanoparticles. Carbohydr. Polym. 2020, 227, 115371. [Google Scholar] [CrossRef] [PubMed]
- Demir, D.; Güreş, D.; Tecim, T.; Genç, R.; Bölgen, N. Magnetic nanoparticle-loaded electrospun poly(ε-caprolactone) nanofibers for drug delivery applications. Appl. Nanosci. 2018, 8, 1461–1469. [Google Scholar] [CrossRef]
- Radacsi, N.; Campos, F.D.; Chisholm, C.R.I.; Giapis, K.P. Spontaneous formation of nanoparticles on electrospun nanofibres. Nat. Commun. 2018, 9, 1659–1667. [Google Scholar] [CrossRef]
- Azimi, B.; Bafqi, M.S.S.; Fusco, A.; Ricci, C.; Gallone, G.; Bagherzadeh, R.; Donnarumma, G.; Uddin, M.J.; Latifi, M.; Lazzeri, A.; et al. Electrospun ZnO/Poly(Vinylidene Fluoride-Trifluoroethylene) Scaffolds for Lung Tissue Engineering. Tissue Eng. Part A 2020, 26, 1312–1331. [Google Scholar] [CrossRef]
- Matos, R.J.R.; Chaparro, C.I.P.; Silva, J.C.; Valente, M.A.; Borges, J.P.; Soares, P.I.P. Electrospun composite cellulose acetate/iron oxide nanoparticles non-woven membranes for magnetic hyperthermia applications. Carbohydr. Polym. 2018, 198, 9–16. [Google Scholar] [CrossRef]
- Ding, B.; Kim, C.K.; Kim, H.Y.; Seo, M.K.; Park, S.J. Titanium dioxide nanofibers prepared by using electrospinning method. Fibers Polym. 2004, 5, 105–109. [Google Scholar] [CrossRef]
- Mayorga, J.L.C.; Rovira, M.J.F.; Mas, L.C.; Moragas, G.S.; Cabello, J.M.L. Antimicrobial nanocomposites and electrospun coatings based on poly(3-hydroxybutyrate-co-3-hydroxyvalerate) and copper oxide nanoparticles for active packaging and coating applications. J. Appl. Polym. Sci. 2018, 135, 45673. [Google Scholar] [CrossRef]
- Ghosal, K.; Agatemor, C.; Špitálsky, Z.; Thomas, S.; Kny, E. Electrospinning tissue engineering and wound dressing scaffolds from polymer-titanium dioxide nanocomposites. Chem. Eng. J. 2019, 358, 1262–1278. [Google Scholar] [CrossRef]
- Wu, H.; Pan, W. Preparation of Zinc Oxide Nanofibers by Electrospinning. J. Am. Ceram. Soc. 2006, 89, 699–701. [Google Scholar] [CrossRef]
- Beregoi, M.; Preda, N.; Costas, A.; Enculescu, M.; Negrea, R.F.; Iovu, H.; Enculescu, I. Synthesis of Core–Double Shell Nylon-ZnO/Polypyrrole Electrospun Nanofibers. Nanomaterials 2020, 10, 2241. [Google Scholar] [CrossRef]
- Rodríguez-Tobías, H.; Morales, G.; Grande, D. Comprehensive review on electrospinning techniques as versatile approaches toward antimicrobial biopolymeric composite fibers. Mater. Sci. Eng. C 2019, 101, 306–322. [Google Scholar] [CrossRef]
- Rodríguez-Tobías, H.; Morales, G.; Ledezma, A.; Romero, J.; Saldívar, R.; Langlois, V.; Renard, E.; Grande, D. Electrospinning and electrospraying techniques for designing novel antibacterial poly(3-hydroxybutyrate)/zinc oxide nanofibrous composites. J. Mater. Sci. 2016, 51, 8593–8609. [Google Scholar] [CrossRef]
- Rodríguez-Tobías, H.; Morales, G.; Maldonado-Textle, H.; Grande, D. Long-term Photo-degradation of Nanofibrous Composites Based on Poly(3-hydroxybutyrate) Electrospun Fibers Loaded with Zinc Oxide Nanoparticles. Fibers Polym. 2022, 23, 2717–2724. [Google Scholar] [CrossRef]
- Yoon, J.; Yang, H.-S.; Lee, B.-S.; Yu, W.-R. Recent Progress in Coaxial Electrospinning: New Parameters, Various Structures, and Wide Applications. Adv. Mater. 2018, 30, 1704765. [Google Scholar] [CrossRef]
- Han, D.; Steckl, A.J. Coaxial Electrospinning Formation of Complex Polymer Fibers and their Applications. ChemPlusChem 2019, 84, 1453–1497. [Google Scholar] [CrossRef]
- Methaapanon, R.; Chutchakul, K.; Pavarajarn, V. Photocatalytic zinc oxide on flexible polyacrylonitrile nanofibers via sol–gel coaxial electrospinning. Ceram. Int. 2020, 46, 8287–8292. [Google Scholar] [CrossRef]
- Buzgo, M.; Mickova, A.; Rampichova, M.; Doupnik, M. Blend electrospinning, coaxial electrospinning, and emulsion electrospinning techniques. In Core-Shell Nanostructures for Drug Delivery and Theranostics; Elsevier: Amsterdam, The Netherlands, 2018; pp. 325–347. [Google Scholar] [CrossRef]
- El-Khatib, E.M.; Ali, N.F.; Nassar, S.H.; El-Shemy, N.S. Functionalization of Natural Fibers Properties by using TiO(2)Nanoparticles to Improve its Antimicrobial Activity. Biointerface Research in Applied Chemistry 2022, 12, 4177–4191. [Google Scholar] [CrossRef]
- Ansari, M.A.; Albetran, H.M.; Alheshibri, M.H.; Timoumi, A.; Algarou, N.A.; Akhtar, S.; Slimani, Y.; Almessiere, M.A.; AlAhmari, F.S.; Baykal, A.; et al. Synthesis of Electrospun TiO2 Nanofibers and Characterization of Their Antibacterial and Antibiofilm Potential against Gram-Positive and Gram-Negative Bacteria. Antibiotics 2020, 9, 572. [Google Scholar] [CrossRef] [PubMed]
- Sekar, A.D.; Kumar, V.; Muthukumar, H.; Gopinath, P.; Matheswaran, M. Electrospinning of Fe-doped ZnO nanoparticles incorporated polyvinyl alcohol nanofibers for its antibacterial treatment and cytotoxic studies. Eur. Polym. J. 2019, 118, 27–35. [Google Scholar] [CrossRef]
- Tiplea, R.E.; Lemnaru, G.M.; Trusca, R.D.; Holban, A.; Kaya, M.G.A.; Dragu, L.D.; Ficai, D.; Ficai, A.; Bleotu, C. Antimicrobial Films based on Chitosan, Collagen, and ZnO for Skin Tissue Regeneration. Biointerface Research in Applied Chemistry 2021, 11, 11985–11995. [Google Scholar] [CrossRef]
- Wang, Y.; Liu, Y.; Qian, Y.; Lv, L.; Li, X.; Liu, Y. Characteristics of MgO/PCL/PVP antibacterial nanofiber membranes produced by electrospinning technology. Surf. Interfaces 2022, 28, 101661. [Google Scholar] [CrossRef]
- Phan, D.-N.; Khan, M.Q.; Nguyen, V.-C.; Vu-Manh, H.; Dao, A.-T.; Thao, P.T.; Nguyen, N.-M.; Le, V.-T.; Ullah, A.; Khatri, M.; et al. Investigation of Mechanical, Chemical, and Antibacterial Properties of Electrospun Cellulose-Based Scaffolds Containing Orange Essential Oil and Silver Nanoparticles. Polymers 2022, 14, 85. [Google Scholar] [CrossRef]
- Aina, S.; Du Plessis, B.; Mjimba, V.; Brink, H. Eggshell Valorization: Membrane Removal, Calcium Oxide Synthesis, and Biochemical Compound Recovery towards Cleaner Productions. Biointerface Research in Applied Chemistry 2022, 12, 5870–5883. [Google Scholar] [CrossRef]
- Jatoi, A.W.; Kim, I.S.; Ogasawara, H.; Ni, Q.-Q. Characterizations and application of CA/ZnO/AgNP composite nanofibers for sustained antibacterial properties. Mater. Sci. Eng. C 2019, 105, 110077. [Google Scholar] [CrossRef]
- Karagoz, S.; Kiremitler, N.B.; Sarp, G.; Pekdemir, S.; Salem, S.; Goksu, A.G.; Onses, M.S.; Sozdutmaz, I.; Sahmetlioglu, E.; Ozkara, E.S.; et al. Antibacterial, Antiviral, and Self-Cleaning Mats with Sensing Capabilities Based on Electrospun Nanofibers Decorated with ZnO Nanorods and Ag Nanoparticles for Protective Clothing Applications. ACS Appl. Mater. Interfaces 2021, 13, 5678–5690. [Google Scholar] [CrossRef]
- Khan, M.Q.; Kharaghani, D.; Nishat, N.; Shahzad, A.; Hussain, T.; Khatri, Z.; Zhu, C.; Kim, I.S. Preparation and characterizations of multifunctional PVA/ZnO nanofibers composite membranes for surgical gown application. J. Mater. Res. Technol. 2019, 8, 1328–1334. [Google Scholar] [CrossRef]
- Zare, H.; Nayebzadeh, S.; Davodiroknabadi, A.; Hataminasab, S.H. Fabrication of Multifunctional Nano Gelatin/Zinc Oxide Composite Fibers. Autex Res. J. 2021, 21, 403–407. [Google Scholar] [CrossRef]
- Munir, M.U.; Mikucioniene, D.; Khanzada, H.; Khan, M.Q. Development of Eco-Friendly Nanomembranes of Aloe vera/PVA/ZnO for Potential Applications in Medical Devices. Polymers 2022, 14, 1029. [Google Scholar] [CrossRef]
- Norouzi, M.A.; Montazer, M.; Harifi, T.; Karimi, P. Flower buds like PVA/ZnO composite nanofibers assembly: Antibacterial, in vivo wound healing, cytotoxicity and histological studies. Polym. Test. 2021, 93, 106914. [Google Scholar] [CrossRef]
- Patel, S.; Konar, M.; Sahoo, H.K.; Hota, G. Surface functionalization of electrospun PAN nanofibers with ZnO–Ag heterostructure nanoparticles: Synthesis and antibacterial study. Nanotechnology 2019, 30, 205704. [Google Scholar] [CrossRef]
- Permyakova, E.S.; Manakhov, A.M.; Kiryukhantsev-Korneev, P.V.; Leybo, D.V.; Konopatsky, A.S.; Makarets, Y.A.; Filippovich, S.Y.; Ignatov, S.G.; Shtansky, D.V. Electrospun Polycaprolactone/ZnO Nanocomposite Membranes with High Antipathogen Activity. Polymers 2022, 14, 5364. [Google Scholar] [CrossRef]
- Chen, Y.; Lu, W.; Guo, Y.; Zhu, Y.; Song, Y. Electrospun Gelatin Fibers Surface Loaded ZnO Particles as a Potential Biodegradable Antibacterial Wound Dressing. Nanomaterials 2019, 9, 525. [Google Scholar] [CrossRef]
- Vázquez, K.; Vanegas, P.; Cruzat, C.; Novoa, N.; Arrué, R.; Vanegas, E. Antibacterial and Antifungal Properties of Electrospun Recycled PET Polymeric Fibers Functionalized with Zinc Oxide Nanoparticles. Polymers 2021, 13, 3763. [Google Scholar] [CrossRef]
- Mosallanezhad, P.; Nazockdast, H.; Ahmadi, Z.; Rostami, A. Fabrication and characterization of polycaprolactone/chitosan nanofibers containing antibacterial agents of curcumin and ZnO nanoparticles for use as wound dressing. Front. Bioeng. Biotechnol. 2022, 10, 1797. [Google Scholar] [CrossRef]
- Li, S.; Yin, J.; Xu, L. Batch Fabrication and Characterization of ZnO/PLGA/PCL Nanofiber Membranes for Antibacterial Materials. Fibers Polym. 2022, 23, 1225–1234. [Google Scholar] [CrossRef]
- Obasi, H.C.; Ijaz, K.; Akhtar, H.; Ali, A.; Khalid, H.; Khan, A.F.; Chaudhry, A.A. Fabrication of antimicrobial electrospun mats using polyvinyl alcohol–zinc oxide blends. Polym. Bull. 2022, 271. [Google Scholar] [CrossRef]

| Type | Advantages | Disadvantages | Ref |
|---|---|---|---|
| Simple electrospinning | polymeric fibers with nanoparticles mainly incorporated (some particles could, however, migrate to the surface of the fibers during the electrospinning process) | limited antibacterial efficacy, which is attributable to the embedding of nanoparticles, which reduces the surface area susceptible to interaction with pathogen microorganisms | [84] |
| Electrospinning/electrospraying | of creating nanoparticle-coated polymeric fibers in a single step | additional equipment (such as electrospraying) is required for the manufacture of composite fibers, which raises the initial technological expenditure | [84] |
| Coaxial electrospinning | include the capacity of miscible and immiscible polymers to produce core-shell nanofibers, the high loading capacity of bioactive chemicals, continuous release from the fibers, and a less abrasive technique that makes it possible to transport vulnerable substances | A technique frequently yields fibers with various characteristics throughout the mesh layer | [90] |
| S. No | Percentage of Bacterial Reduction after 24 h | |
|---|---|---|
| S. aureus | E. coli | |
| 10% PVA/1% aloe vera/0.5% ZnO NPS | 75.5% | 60.9% |
| 10% PVA/2% aloe vera/0.5% ZnO NPS | 79.1% | 73.9% |
| 10% PVA/3% aloe vera/0.5% ZnO NPS | 86.1% | 81.8% |
| 10% PVA/4% aloe vera/0.5% ZnO NPS | 91.2% | 86.9% |
| 10% PVA/0.5% aloe vera/1% ZnO NPs | 93.50% | 83.14% |
| 10% PVA/0.5% aloe vera/2% ZnO NPs | 97.20% | 92.96% |
| 10% PVA/0.5% aloe vera/3% ZnO NPs | 99.80% | 96.87% |
| 10% PVA/0.5% aloe vera/4% ZnO NPs | 100% | 99.20% |
| Sample | Strains | |||
|---|---|---|---|---|
| E. coli (ATCC:25922) | S. aureus (ATCC:6538) | |||
| MIC | MBC | MIC | MBC | |
| PVA/ZnO | 62.5 ± 00 μg/mL | 125 ± 00 μg/mL | 250 ± 00 μg/mL | 250 ± 00 μg/mL |
| PVA | - | - | - | - |
| Ampicillin | 4 ± 00 μg/mL | 16 ± 00 μg/mL | 250 ± 00 μg/mL | 500 ± 00 μg/mL |
Disclaimer/Publisher’s Note: The statements, opinions and data contained in all publications are solely those of the individual author(s) and contributor(s) and not of MDPI and/or the editor(s). MDPI and/or the editor(s) disclaim responsibility for any injury to people or property resulting from any ideas, methods, instructions or products referred to in the content. |
© 2023 by the authors. Licensee MDPI, Basel, Switzerland. This article is an open access article distributed under the terms and conditions of the Creative Commons Attribution (CC BY) license (https://creativecommons.org/licenses/by/4.0/).
Share and Cite
Preda, M.D.; Popa, M.L.; Neacșu, I.A.; Grumezescu, A.M.; Ginghină, O. Antimicrobial Clothing Based on Electrospun Fibers with ZnO Nanoparticles. Int. J. Mol. Sci. 2023, 24, 1629. https://doi.org/10.3390/ijms24021629
Preda MD, Popa ML, Neacșu IA, Grumezescu AM, Ginghină O. Antimicrobial Clothing Based on Electrospun Fibers with ZnO Nanoparticles. International Journal of Molecular Sciences. 2023; 24(2):1629. https://doi.org/10.3390/ijms24021629
Chicago/Turabian StylePreda, Manuela Daniela, Maria Leila Popa, Ionela Andreea Neacșu, Alexandru Mihai Grumezescu, and Octav Ginghină. 2023. "Antimicrobial Clothing Based on Electrospun Fibers with ZnO Nanoparticles" International Journal of Molecular Sciences 24, no. 2: 1629. https://doi.org/10.3390/ijms24021629
APA StylePreda, M. D., Popa, M. L., Neacșu, I. A., Grumezescu, A. M., & Ginghină, O. (2023). Antimicrobial Clothing Based on Electrospun Fibers with ZnO Nanoparticles. International Journal of Molecular Sciences, 24(2), 1629. https://doi.org/10.3390/ijms24021629

